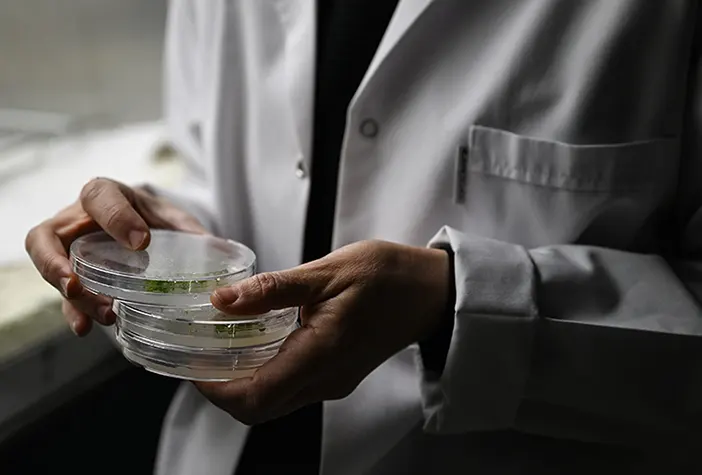
alper-gezeravci-uzayda-tarim-deneyi-yapacak-002.webp

İlk Türk astronot Alper Gezeravcı'nın, Uluslararası Uzay İstasyonu'ndaki ilk deneyini oluşturan tuz stresine maruz bırakılan bitkilerle ilgili deney, gelecekte Ay ve Mars'ta kurulabilecek koloniler için tarımsal çalışmalara ışık tutacak.
Yaşar Üniversitesi Tarım Bilimleri ve Teknolojileri Fakültesi Dekan Vekili Prof. Dr. İsmail Türkan, Ege Üniversitesi öğretim üyeleri Doç. Dr. Rengin Özgür Uzilday ve Doç. Dr. Barış Uzilday'ın proje yöneticisi olduğu "Ekstrem Halofit olan Schrenkiella Parvulanın Tuz Stresine Verdiği Yanıtların Uzay Ortamında Araştırılması" deneyi, Gezeravcı'nın uzaydaki ilk deneyi oldu.

Deneyle Tuz Gölü'nde endemik olarak yetişen "Schrenkiella Parvula" bitkisinin uzay ortamında tuz ve diğer stres etkenlerine verdiği tepkiler görülecek.
Deneyi geliştiren ekipte yer alan Doç. Dr. Barış Uzilday, bitki üzerinde yaklaşık 10 yıl önce, toprak tuzluluğunun tarımsal üretimin önünde önemli engellerden biri olması nedeniyle çalışmaya başladıklarını söyledi.
Toprak tuzluluğunun gün geçtikçe artan bir çevresel stres faktörü olduğuna dikkati çeken Uzilday, çalışmalarla bu bitkinin tuzlu ortama nasıl adapte olduğunu anlamaya, bunun mekanizmalarını çözüp bu bilgileri tarım bitkilerinin tuz stresine verdikleri yanıtları değiştirerek tuz stresi toleranslarını arttırmak için kullanmayı amaçladıklarını ifade etti.

Bu bitkilerin topraktaki tuzu depolaması nedeniyle tuzu uzaklaştırma amaçlı da kullanılabileceğine dikkati çeken Uzilday, "Bu uzaklaştırma, uzayda tarım yapmaya karar verdiğimizde veya ihtiyaç duyduğumuzda yani Ay ya da Mars'ta koloniler kurmaya başladığımızda gerekli olacak. Oradaki yapı toprak değil aslında, çünkü toprak organik, inorganik maddeleri içeren ve içinde mikroorganizmalar olan canlı bir yapıdır. Ay ve Mars'ta bulunan regolit olarak adlandırılıyor ve canlılık hiç içermiyor. Bu bitki, regolitlerin tarım yapılabilir hale getirilebilmesi için, uzay ortamına adapte olup orada öncül bitki olarak kullanılıp bu toprakların ıslah edilmesinde potansiyeli bulunan bir bitki." diye konuştu.
"Bitkiler orada çimlenecek"
Deneyle bu bitkinin yer çekimli dünyada gözlemlediğimiz tolerans karakterini uzay ortamında da sürdürüp sürdüremeyeceğinin test edileceğini dile getiren Uzilday, "Bitkinin dünyada gördüğümüz karakterleri uzay ortamında sürdürülebilecek mi, biz gerçekten bu bitkileri öncül bitkiler olarak kullanabilir miyiz, bu toprakların ıslahında bunlar bize bir araç olabilecek mi? Bu deney bize bunun bir parçasını gösterecek." dedi.
Uzilday, yaklaşık 120 tohumun mikro yer çekiminde, uluslararası uzay istasyonunda çimlenmesini istediklerini belirterek, şöyle konuştu:
"Bu nedenle tohumları soğuk ortamda ve karanlıkta gönderdik. Bu tohumlar karanlık ve ışıksız ortamda çimlenmiyorlar. Kennedy Uzay Merkezi'nde bize tahsis edilen laboratuvarda bu deneyi kurup teslim ettim fırlatma için. Uluslararası özel istasyonuna kadar soğukta taşındı. Alper Bey orada bizim planladığımız bitki büyütme ortamına, bitkinin gerektirdiği sıcaklık ve ışık şiddetine bunların aktarımını yaptı. Bitkilerin artık çimlenmeye başladığını düşünüyoruz. Bitkiler orada büyüyecekler. Deneyin sonunda Alper Bey bu örnekleri hasat edecek. Bunları bir fiksasyon sıvısı içinde sabitleyecek. Yani bütün metabolik aktivite duracak bitkilerde. Böylelikle biz aslında bu bitkilerin mikro yer çekimi altında tuz stresine maruz kaldıklarında hücrelerinde ortaya çıkan değişikliklerin resmini çekmiş olacağız. Bu örnekler laboratuvarımıza geldiğinde de bunların büyüme performansları, morfolojik değişiklikleri göreceğiz. Bulacağımız yanıt şu; yer çekimi ortamında bitkinin oluşturduğu tuz stresine verdiği yanıtlar ile mikro yer çekimi sırasında oluşturduğu yanıtlar arasında bütün metabolik yolaklarda ortaya çıkan değişiklikler nedir? Bu bitki hangi yolakları kullanarak bu ortama adapte oluyor, bunu ortaya çıkarmış olacağız."
"İnsanlık için faydalı olabilecek sonuçlar doğurma potansiyeli var"
Doç. Dr. Barış Uzilday, bitkinin orada kazandığı biyokütlenin kendileri için çok anlamlı olacağını vurgulayarak, bunun bitkinin büyüme performansını göstereceğini söyledi.

Bitkinin bulunduğu ortamdaki koşullara uyum sağlaması halinde büyümesinin stressiz koşullara göre az etkilenmesini beklediklerini dile getiren Uzilday, şu değerlendirmede bulundu:
"Eğer stres koşulları bitki üzerinde olumsuz etkilere sahipse biyokütle düşecektir. Bizim test etmek istediğimiz önemli şeylerden bir tanesi bu. Yani bizim Tuz Gölü'nde büyüyen bu bitkimiz mikro yer çekimi koşullarında bu stres toleransını devam ettirebilecek mi? Eğer ettirebiliyorsa bu çok iyi. Çünkü o zaman hem yaşam destek sistemlerinde hem de Ay ve Mars'taki regolitlerde öncül bitki olarak kullanılma potansiyelinin yüksek olduğunu gösterir.
Başka bir sonuç ise bu karakterini sürdüremediği tuz stresine daha hassas hale geldiği olur. Bu bitkinin kullanılamaz hale geldiği anlamına gelmez. Bunun dışında mikro yerçekimi koşulları altında aktifleşen bazı genler var. Bu genlerin dünyada da stresli koşullarda tolerans sağladığı gösterilmiş. Bu tarz genlerin keşfedilmesi de mümkün. İnsanlık için faydalı olabilecek sonuçlar doğurma potansiyeli var."

"Orada boncuk boncuk gözyaşlarımız döküldü"
Uzay aracının fırlatılması anındaki hislerini de aktaran Uzilday, o an Türkiye'den gidenler olarak çok yoğun duygular yaşadıklarını aktardı.
Uzilday, projesinin seçilmesinin ve uzaya gitmesinin gururunu yaşadığını dile getirerek, "Uzayda çok basit diye adlandırabileceğiniz bir deneyi yapmak çok kompleks. Çünkü her basamağın çok hassas tasarlanması gerekiyor. İkinci bir şansınız yok. O yüzden çok yoğun bir hazırlık süreci geçirdik. Bu bizi yordu diyebilirim. Ama o fırlatma anını görünce insan yoğun duygular yaşıyor. Orada boncuk boncuk gözyaşlarımız döküldü. Çok tarihi bir an. Oradakiler 'Türkiye'nin milli uzay programında, Türkiye'nin bu uzaya yaptığı hamlede benim de katkım var, ben de oradaydım.' diyebilecekler. Biz de o gururu taşıyoruz."
Doç. Dr. Rengin Özgür Uzilday ise deneyin insanlık için önemli sonuçlar vereceğini belirterek, yaşadığı mutluluğu dile getirdi.


Kaynak: